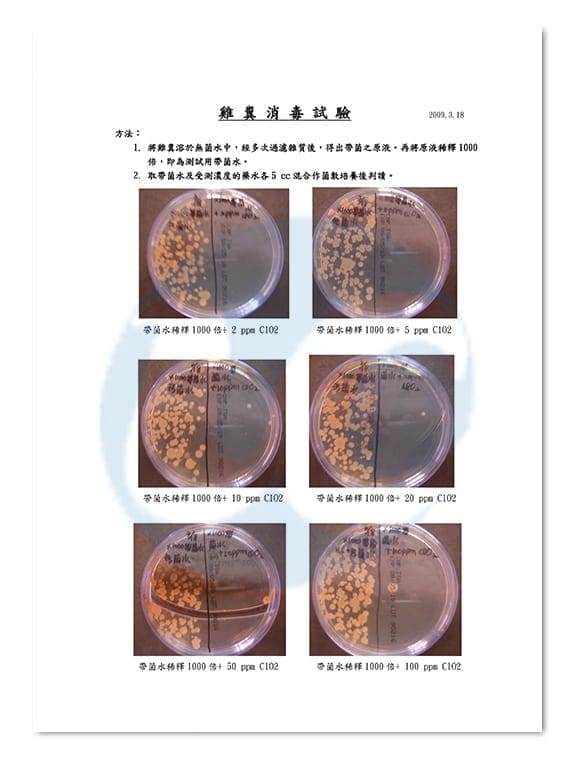

It is tested effectively killing 99.999% of common pathogenic bacteria such as E. coli, Staphylococcus aureus, and influenza virus in concentration from 5~20 ppm in laboratory standard tests.
Direction for Use (UC300)
- Clean the surface to be treated.
- Moisten a microfiber cloth with UC300.
- Wet the surface to be disinfected with the cloth and leave a moist film. Porous surfaces or absorbent materials can be sprayed instead of wiped.
- If droplets remain on surface, wipe with a cloth to avoid dust gathered into the droplets and leave stains afterward.
- Let the moist surface dry. Rinsing is not necessary.
- UC300 is not suitable to apply on metal surface. If it is accidentally spilled onto metal surface, wipe with dry cloth before it dries out.
UC300 20L package is available for channel partners. Contact us for details.
Precautions:
- This product is appliance surface disinfectant. Do not use it orally or on skin.
- Please keep out of reach of children and store in a cool place. Away from direct sunlight and shaking.
- Do not use UC300 on metal.
- If accidentally get into eyes, immediately flush eyes with tap water or see a doctor.
- Do not dilute UC300 with tap nor mineral water as they would reduce disinfection effectiveness.
Sterilization in Private Space
For private space like typical households and office desks, in which the risk of infection is typically much lower than in public space, you may dilute UC300 with distilled or RO water to 50 ppm (1:5).
The Technology
When lightning strikes the ocean, high concentrations of chlorine dioxide gas are created. The gas can directly and efficiently destroy viruses and bacteria. However, the gas is too easy to dissolve in water reducing much of its germicidal power.
This sterilizing liquid is using patented nano-tech from Taiwan to have enormous amount of invisible bubbles keeping gaseous ClO2 in active status.
As a result, this colloidal product has much extended shelf-life in comparison to others and is keeping with highest sterilization power till the last drop in bottle.
Generally speaking bleach needs to have a concentration over 1,000 ppm to have a comprehensive germicidal effect, and alcohol needs 75% or above.
Our sterilizing liquid needs only 20ppm to get the same result. So, its application is much friendlier to living environment as well as to metal surfaces.